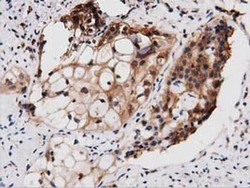

Antibody data
- Antibody Data
- Antigen structure
- References [0]
- Comments [0]
- Validations
- Immunocytochemistry [2]
- Immunohistochemistry [6]
Submit
Validation data
Reference
Comment
Report error
- Product number
- MA5-25242 - Provider product page

- Provider
- Invitrogen Antibodies
- Product name
- PEPD Monoclonal Antibody (OTI1B7)
- Antibody type
- Monoclonal
- Antigen
- Recombinant full-length protein
- Reactivity
- Human
- Host
- Mouse
- Isotype
- IgG
- Antibody clone number
- OTI1B7
- Vial size
- 100 µL
- Concentration
- 1.00 mg/mL
- Storage
- -20°C, Avoid Freeze/Thaw Cycles
No comments: Submit comment
Supportive validation
- Submitted by
- Invitrogen Antibodies (provider)
- Main image

- Experimental details
- Immunofluorescent analysis of PEPD in COS7 cells. Cells were transfected with a plasmid overexpressing PEPD and probed with a PEPD monoclonal antibody (Product # MA5-25242).
- Submitted by
- Invitrogen Antibodies (provider)
- Main image

- Experimental details
- Immunofluorescent analysis of PEPD in COS7 cells. Cells were transfected with a plasmid overexpressing PEPD and probed with a PEPD monoclonal antibody (Product # MA5-25242).
Supportive validation
- Submitted by
- Invitrogen Antibodies (provider)
- Main image

- Experimental details
- Immunohistochemistry was performed on paraffin-embedded human bladder tissue. To expose target proteins, 10mM citric buffer, pH6.0, 100°C for 10min was used. Following antigen retrieval, tissues were probed with a PEPD monoclonal antibody (Product # MA5-25242) at a dilution of 1:50.
- Submitted by
- Invitrogen Antibodies (provider)
- Main image

- Experimental details
- Immunohistochemistry was performed on paraffin-embedded human lymph node tissue. To expose target proteins, 10mM citric buffer, pH6.0, 100°C for 10min was used. Following antigen retrieval, tissues were probed with a PEPD monoclonal antibody (Product # MA5-25242) at a dilution of 1:50.
- Submitted by
- Invitrogen Antibodies (provider)
- Main image

- Experimental details
- Immunohistochemistry was performed on paraffin-embedded human kidney tissue. To expose target proteins, 10mM citric buffer, pH6.0, 100°C for 10min was used. Following antigen retrieval, tissues were probed with a PEPD monoclonal antibody (Product # MA5-25242) at a dilution of 1:50.
- Submitted by
- Invitrogen Antibodies (provider)
- Main image

- Experimental details
- Immunohistochemistry was performed on paraffin-embedded carcinoma of human bladder tissue. To expose target proteins, 10mM citric buffer, pH6.0, 100°C for 10min was used. Following antigen retrieval, tissues were probed with a PEPD monoclonal antibody (Product # MA5-25242) at a dilution of 1:50.
- Submitted by
- Invitrogen Antibodies (provider)
- Main image

- Experimental details
- Immunohistochemistry was performed on paraffin-embedded human liver tissue. To expose target proteins, 10mM citric buffer, pH6.0, 100°C for 10min was used. Following antigen retrieval, tissues were probed with a PEPD monoclonal antibody (Product # MA5-25242) at a dilution of 1:50.
- Submitted by
- Invitrogen Antibodies (provider)
- Main image
- Experimental details
- Immunohistochemistry was performed on paraffin-embedded carcinoma of human pancreas tissue. To expose target proteins, 10mM citric buffer, pH6.0, 100°C for 10min was used. Following antigen retrieval, tissues were probed with a PEPD monoclonal antibody (Product # MA5-25242) at a dilution of 1:50.
 Explore
Explore Validate
Validate Learn
Learn Western blot
Western blot Immunocytochemistry
Immunocytochemistry Flow cytometry
Flow cytometry